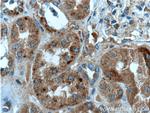
FAHD1 Antibody in Immunohistochemistry (Paraffin) (IHC (P))
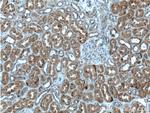
FAHD1 Antibody in Immunohistochemistry (Paraffin) (IHC (P))

Search
Proteintech
FAHD1 Polyclonal Antibody
{{$productOrderCtrl.translations['antibody.pdp.commerceCard.promotion.promotions']}}
{{$productOrderCtrl.translations['antibody.pdp.commerceCard.promotion.viewpromo']}}
{{$productOrderCtrl.translations['antibody.pdp.commerceCard.promotion.promocode']}}: {{promo.promoCode}} {{promo.promoTitle}} {{promo.promoDescription}}. {{$productOrderCtrl.translations['antibody.pdp.commerceCard.promotion.learnmore']}}
产品信息
26233-1-AP
种属反应
宿主/亚型
分类
类型
抗原
偶联物
形式
浓度
规格
纯化类型
保存液
内含物
保存条件
运输条件
产品详细信息
Immunogen sequence: ADHVREMRS AVLSEPVLFL KPSTAYAPEG SPILMPAYTR NLHHELELGV VMGKRCRAVP EAAAMDYVGG YALCLDMTAR DVQDECKKKG LPWTLAKSFT ASCPVSAFVP KEKIPDPHKL KLWLKVNGEL RQEGETSSMI FSIPYIISYV SKIITLEEGD IILTGTPKGV GPVKENDEIE AGIHGLPKVS SATLPVRLQE (28-226 aa encoded by BC063017)
靶标信息
Probable mitochondrial acylpyruvase which is able to hydrolyze acetylpyruvate and fumarylpyruvate in vitro (PubMed:15551868, PubMed:21878618). Also has oxaloacetate decarboxylase activity (PubMed:25575590). [UniProt]
仅用于科研。不用于诊断过程。未经明确授权不得转售。
篇参考文献 (0)
生物信息学
蛋白别名: Acylpyruvase FAHD1; acylpyruvase FAHD1, mitochondrial; acylpyruvate hydrolase; DKFZP566J2046; FAH domain-containing protein 1; Fumarylacetoacetate hydrolase domain-containing protein 1; OAA decarboxylase; Oxaloacetate decarboxylase; oxaloacetate decarboxylase, mitochondrial; Oxaloacetate tautomerase FAHD1, mitochondrial; unnamed protein product; YISK like/RJD15; YisK-like protein
基因别名: C16orf36; FAHD1; ODx; YISKL
UniProt ID: (Human) Q6P587
Entrez Gene ID: (Human) 81889